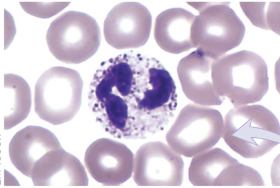
<p>granulocyte</p><ul><li><p>4 lobes</p></li></ul>
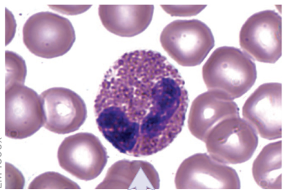
<p>granulocyte</p><ul><li><p>1-2 lobes</p></li><li><p>pinkish stain</p></li></ul>
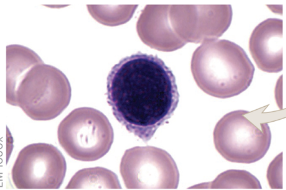
<p>agranulocyte</p><ul><li><p>looks black under microscope</p></li></ul>
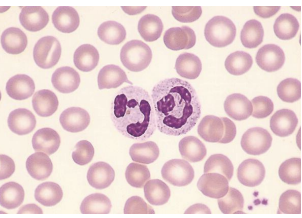
<p>what blood cells are these?</p>
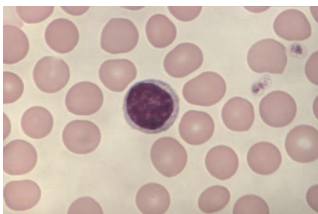
<p>what blood cells are these?</p>
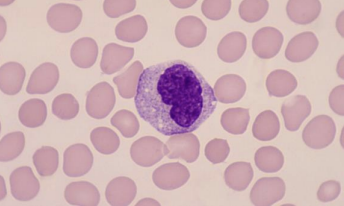
<p>what blood cells are these?</p>
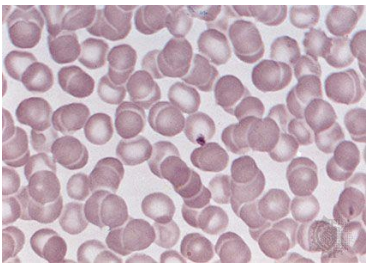
<p>what are the abundant cells?</p>
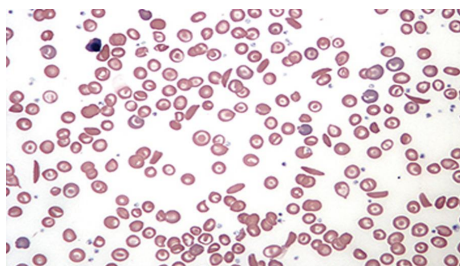
<p>name 1 major abnormal cell</p>

A&P Midterm
1/92
There's no tags or description
Looks like no tags are added yet.
Name | Mastery | Learn | Test | Matching | Spaced | Call with Kai |
|---|
No analytics yet
Send a link to your students to track their progress
93 Terms

1
parathyroid gland

2
thyroid gland

3
thymus

4
adrenal cortex

5
adrenal medulla

6
testes

7
pineal gland

8
hypothalamus

9
pituitary gland

10
pancreas

11
ovaries
primary endocrine gland
only works with the endocrine system; not apart of another system in the body
secretion of hormones
secondary endocrine gland
primary function other than the secretion of hormones
pancreas (digestive system)
skin
kidney

Anterior Pituitary Gland (13)
secretes hormones

Posterior Pituitary Gland (15)
stores hormones
pineal gland
sleep-wake cycle
primary endocrine gland
thyroid gland
storage of thyroid hormones
primary endocrine gland
thyroxine (follicular)
calcitocin (parafollicular)
adrenal gland
primary endocrine gland
adrenal cortex
zona glomerulosa
zona fasciculata
zona reticularis
adrenal medulla
epinephrine secretion
adrenaline

pancreas
secretion
secondary endocrine gland

granulocytes
HAVE granules
neutrophil
granulocyte
4 lobes
basophil
granulocyte
1-2 lobes

eosinpohil
granulocyte
1-2 lobes
pinkish stain
agranulocytes
NO granules
lymphocyte
agranulocyte
looks black under microscope
monocyte
agranulocyte
white blood cells

Artery
oxygenated blood
red
vein
non-oxygenated blood
blue
location of heart
cardiac cavity
sternum is anterior to heart
heart is posterior to trachea and esophagus
pericardium layer
OUTSIDE the heart
fibrous pericardium
parietal and visceral layer of serous pericardium

endocardium
INSIDE the heart
endocardium
myocardium
epicardium

ascending aorta
main blood supply to all parts of the body
descending aorta
supplies to lower extremity
3 blood vessels
left ventricle
forms apex of the heart (curved bottom)
pumps blood to aorta
right ventricle
forms base of the heart
pumps blood to pulmonary trunk
superior vena cava
takes oxygenated blood from upper limb to right atrium
inferior vena cava
takes oxygenated blood from lower limb to left atrium
auscultation
listening to the heart sound
S1
lub sound
closure of AV valves
S2
dub sound
closure of SV valves
Bicuspid Valve (mitral valve)
left atrium —> left ventricle
Atrioventricular Valve (AV)
Tricuspid Valve
right atrium —> right ventricle
Atrioventricular Valve (AV)
Aortic Valve
left ventricle —> aorta
semilumar valve (SV)
Pulmonary Valve
right ventricle —> pulmonary artery
semilumar valve (SV)
pulse
contraction of blood vessels at various points
cartoid artery
neck artery

radial and ulnar artery
wrist artery

brachial artery
upper limb artery

temporal artery
head artery

popliteal artery
..

bradycardia
slow heart rate
lower than 60 bpm
tachycardia
fast heart rate
higher than 100 bpm
2 hormones produced by pancreas
insulin
glucogen
what is the clinical term for low red blood cell count and elevated white blood cell count
Leukocytosis = high white blood cell count
Anemia = low red blood cell count
Which gland is responsible for melatonin secretion?
pineal gland

what blood type is Ben? Marissa?
ben: O+
marissa: A-
what hormone does the pineal gland produce?
melatonin
what hormone does the small intestine produce?
cholecystokinin (CCK)
what hormone does the testes produce?
testosterone
what hormone does the hypothalamus produce?
vasopressin
what hormone does the stomach produce?
ghrelin
what hormone does the ovaries produce?
progesterone
what hormone is responsible for excessive growth? where is is located?
growth hormone
anterior pituitary gland
two hormones involved in glucose metabolism
glucagon
insulin
what hormones are secreted by the posterior pituitary gland?
oxytocin
antidiuretic hormone
After extensive exercise, a diabetic is feeling dizzy, sweating, shaky, and tired. What is this called? What could this person do to improve the situation?
Hypoglycemia- too little blood sugar
Have the person consume food or drink containing glucose
normoglycemic
having normal blood sugar levels
hyperglycemia
too much blood sugar
headaches
blurred vision
to fix: insulin and regular exercise
3 major branches of the aorta above the diaphragm
brachiocephalic trunk
left common cartoid artery
left subclavian artery

name the heart sound in region A
dupp (S2)

name the heart sound in region B
dupp (S2)

name the heart sound in region C
lub (S1)

name the heart sound in region D
lub (S1)

identify vessel C and D
C: artery
D: vein

name 2 differences between C and D
arteries have thicker tunica media
high pressure system
5 places where pulse can be found in the body
radial artery
ulnar artery
carotid artery
temporal artery
brachial artery
what is the range of a normal heart rate in a human?
60-100 bpm
bone marrow suppression/immunosuppresive therapy
causes anemia
fewer blood cells are made in the bone marrow
phlebotomy
puncturing a vein
for the purpose of drawing blood

what region is A
aortic valve

what region is P
pulmonary valve

what region is T
tricuspid valve

what region is M
bicuspid valve

identify A and B
A: thyroid gland
B: parathyroid hormone

what hormones are secreted by A
thyroid hormone

what is the function of the hormone secreted by B
calcium regulation/homeostasis
what blood cells are these?
neutrophil
what blood cells are these?
lymphocyte
what blood cells are these?
monocyte
what are the abundant cells?
normal red blood cells
name 1 major abnormal cell
sickled red blood cell
primary endocrine organs (4)
adrenal
pituitary
thyroid
parathyroid
secondary endocrine organs (7)
pancreas
skin
testes
kidney
hypothalamus
pineal
stomach